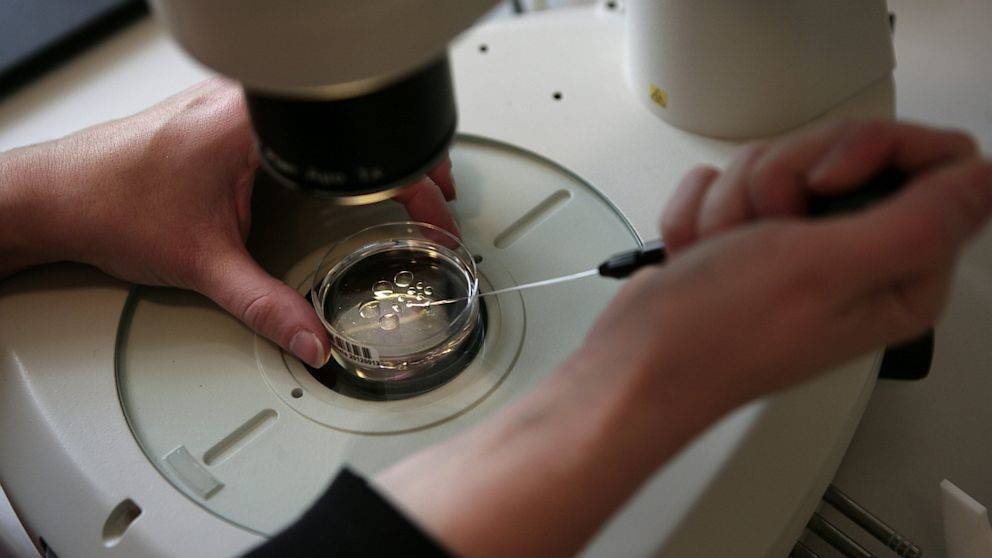
Подсадка эмбрионов по ЭКО: как происходит перенос в матку, на какой день цикла делают, каковы шансы?

Сколько эмбрионов лучше переносить?
Перед врачом всегда стоит непростой вопрос: сколько эмбрионов лучше перенести, чтобы добиться хорошего шанса наступления беременности, но при этом избежать многоплодия. С одной стороны, чем больше эмбрионов, тем с большей вероятностью женщина забеременеет. С другой, мы не можем перенести сразу все. Потому что в такой ситуации наверняка возникнет многоплодная беременность. Она имеет высокий риск осложнений, и в целом тяжело переносится женщиной. К тому же, не все родители готовы к появлению на свет сразу двух детей.
Несколько десятилетий назад основным методом повышения эффективности процедуры ЭКО было увеличение количества переносимых эмбрионов. Но те времена давно ушли. Появилось множество других способов достичь хороших показателей преодоления бесплодия, и при этом избежать многоплодия. В хорошей клинике много эмбрионов не переносят никогда. Во всём мире отмечаются тенденции к уменьшению их количества.
В большинстве стран Запада больше двух переносить запрещено вообще. В скандинавских государствах нельзя делать перенос более одного эмбриона женщинам 34 лет и младше. В то время как в России по-прежнему некоторые клиники переносят сразу три, а иногда и больше. В основном так поступают в случае множественных неудачных попыток ЭКО, особенно у возрастных женщин.
В последние годы всё чаще используется селективный перенос одного эмбриона. Исследования показывают, что при переносе двух и более шансы наступления беременности если увеличиваются, то лишь минимально. При этом риск многоплодия возрастает многократно. Вероятно, это связано с тем, что в наибольшей степени вероятность беременности зависит от состояния матки на момент проведения процедуры. Если делать перенос на эндометрий, который не находится в своем оптимальном состоянии, то беременность не наступит в любом случае, вне зависимости от количества перенесенных бластоцист.
Таким образом, в хорошей клинике:
- в подавляющем большинстве случаев переносят только один эмбрион;
- больше одного – в основном у женщин от 35 лет;
- для повышения эффективности ЭКО используют не увеличение количества бластоцист на перенос, а другие методы (отслеживание состояния эндометрия, дополнительные вспомогательные репродуктивные технологии – ПИКСИ, ПГД, вспомогательный хетчинг и т.д.).
Что это такое?
Само оплодотворение при ЭКО свершается не в пробирке, несмотря на устоявшееся определение, а в чаше Петри – специальной емкости, в которую помещают половые клетки мужчины и женщины. Иногда встречу сперматозоиды и яйцеклетки приходится «организовывать» вручную – методом ИКСИ. Если оплодотворение состоялось, уже через 14 часов наблюдаются начальные метаморфозы в структуре яйцеклетки. Далее начинается культивирование зародышей.
Выращивание эмбрионов под бдительным наблюдением эмбриологов проходит несколько дней. Перенос «подросших» зародышей в матку производится тогда, когда по мнению репродуктолога и эмбриолога, наступает наиболее благоприятное для этого время.
Сам перенос бывает стандартным, двойным и комбинированным. При стандартном переносе процедура проводится один раз в назначенный день. При двойном подсадку осуществляют дважды – сначала подсаживают эмбрион, который культивировался 2-3 дня после оплодотворения, а затем подсаживают эмбрион, который достиг стадии бластоцисты (5-6 день после оплодотворения). Двойной перенос повышает шансы пары на долгожданную беременность. Но есть и обратная сторона медали – ранее перенесенный эмбрион может «выпасть», его смоет раствором. Также повышается вероятность многоплодия.


Комбинированный перенос повышает шансы на зачатие при повторном протоколе после неудачного. При нем вводят два вида эмбрионов – свежие, полученные в текущем протоколе, и криоконсервированные, которые заморозили еще в предыдущем протоколе или даже ранее. Такую подсадку наиболее часто делают в естественном цикле, без предшествующей гормональной стимуляции яичников.
При успешном протоколе через несколько дней происходит перенесенных зародышей в матку. Эмбрион приживается и начинается полноценная, вполне обычная беременность.
Подготовка к переносу
При отборе наиболее сильных и жизнеспособных зародышей учитывают количество делений, скорость дробления, отсутствие отклонений в развитии. Существует несколько факторов, по которым определяют день переноса. Учитывают степень созревания эмбриона, возраст матери, индивидуальные особенности ее организма. Если возраст матери превышает 35 лет, а ранее у нее были неудачные попытки оплодотворения, перенос осуществляют на 5 сутки. Поскольку производят подсадку нескольких эмбрионов, риск многоплодия при ЭКО увеличивается до 25 %.
Самые распространенные вопросы, которые возникают у пациенток перед манипуляцией: как подготовиться к переносу эмбрионов? стоит ли пить воду? что взять с собой? болезненна ли процедура? можно ли кушать?
Специальная подготовка не требуется, но нужно соблюдать следующие правила:
- принять душ без агрессивных косметических средств;
- за 2-3 часа до переноса выпить несколько стаканов воды, чтобы наполнить мочевой пузырь;
- не наносить макияж и не пользоваться парфюмерией в день процедуры;
- сдать кровь на прогестерон;
- съесть легкий завтрак.
Как происходит перенос эмбрионов при ЭКО, и что при этом испытывает пациентка?
Сама процедура переноса абсолютно безболезненна, поэтому какая-либо анестезия не требуется. Обычно перенос производят в утреннее время. Пациентка располагается в гинекологическом кресле. Подсаживание эмбрионов производят при помощи катетера с прикрепленным туберкулиновым шприцем. Весь процесс происходит под контролем УЗИ.

Длительность манипуляции составляет 3-5 минут. После катетер вынимают и передают для анализа эмбриологу. Специалист должен убедиться в том, что все эмбрионы были внедрены в матку. Успешная имплантация зависит от нескольких факторов: насколько тщательно была проведено удаление цервикальной слизи, качества эмбрионов, мягкости катетера, мастерства врача.
Двойной перенос эмбрионов значительно увеличивает шансы на беременность. Его осуществляют на второй и пятый или на третий и шестой дни развития зародышей. Вероятность успешной имплантации увеличивается более чем на 50 %. Однако именно после двойного переноса часто развивается многоплодная беременность. Если для многих пар этот факт расценивается как преимущество, для других он будет нежелательным, ведь некоторым женщинам может быть противопоказано вынашивание двойни или тройни. Также врачи отмечают возрастание риска развития внематочной беременности.
Сколько нужно лежать после переноса эмбрионов?
Обычно пациентке рекомендуют остаться на некоторое время в клинике и полежать примерно 30 минут. Однако, это время необходимо больше в качестве психологической разрядки, поскольку оно никак не может повлиять на эффективность ЭКО.
Как подготовиться к ЭКО
Процедура довольно дорогостоящая и трудоемкая, вот почему перед экстракорпоральным оплодотворением проводится подготовительный период. Мужчина и женщина поэтапно исправляют образ жизни и проходят обследование. Последовательность мероприятий определяет лечащий врач.
Женщине
Начать подготовку к ЭКО следует с прохождения полного обследования. Представительнице слабого пола придется сдать большой список исследований, чтобы попытка переноса эмбриона окончилась успешно.
В такой перечень входит:
- Клинический анализ крови (содержание клеток крови, гемоглобина и СОЭ).
- Общий анализ мочи.
- Биохимический анализ крови.
- Гемостазиограмма.
- Анализ на гормоны (прогестерон и эстрогены в плазме, исследование АМГ, ФСГ).
- Мазок на флору.
- ПЦР-диагностика.
- Серологическое исследование антител к TORCH-инфекции, ВИЧ, гепатиту В, С.
- Анализ крови на RW.
- Мазок на онкоцитологию.
- Флюорография легких.
- ЭКГ.
- УЗИ органов малого таза, выполненное трансвагинально.
- Маммография.
- Кольпоскопия.
- Гистеросальпингография (для визуализации проходимости фаллопиевых труб).
Во время подготовки к процедуре женщины, страдающие общими заболеваниями, должны пройти консультацию профильных специалистов. При наличии у супружеской пары многократных выкидышей или замерших беременностей, детей с аномалиями развития или наследственными отклонениями назначают осмотр генетика. Доктор рекомендует сдачу анализа на кариотипирование – исследование качества и числа хромосом обоих партнеров.
Некоторые врачи советуют пройти процедуру плазмолифтинга, утверждая, что метод повышает успешность прикрепления эмбриона в ходе ЭКО и наступление беременности.
Мужчине
Для подготовки к экстракорпоральному оплодотворению представителям сильного пола придется сдавать следующие анализы:
Спермограмма: обратите внимание, что перед тестом воздержание от секса составляет 2-7 суток.
Анализ крови на определение антител к ВИЧ, гепатиту В, С.
Мазок из уретры на наличие половой инфекции.
Анализ крови на RW.
Цитологический анализ мазка из уретры на наличие атипичных и туберкулезных клеток.
Ультразвуковое исследование органов мошонки, простаты.
Анализ фрагментации ДНК сперматозоидов.
При наличии заболеваний мочеполовой системы мужчина идет на консультацию уролога и андролога.
Причины неудачного ЭКО
Среди основных причин неудачной попытки экстракорпорального оплодотворения выделяют:
- возраст матери старше 35 лет;
- увеличение количества фолликулостимулирующего гормона;
- индивидуальная непереносимость или развитие побочных реакций на лекарственные препараты, которые принимаются для улучшения фертильности;
- недостаточное количество полученных яйцеклеток и эмбрионов для выполнения пересадки;
- неправильный выбор времени для подсадки эмбрионов.
Причины временного характера
Образ жизни, питание, стрессы, другие факторы и их сочетания оказывают влияние на результаты лечения. Наибольшее влияние на функционирование репродуктивной системы оказывают:
- Химио- и лучевая терапия.
- Операции.
- Вредные привычки.
- ОРЗ и лекарства.
- Питание.
Перечисленные факторы носят временный характер. Если какой-то из них стал причиной неудачной попытки ЭКО, то вероятно, в следующий раз желанный результат будет достигнут.
Плохое качество эмбрионов
Эмбрионы из 6-8 клеток, характеризующиеся высокими показателями деления, являются наиболее подходящими для успешной процедуры. Если причиной неудачи является плохое качество эмбрионов, то рекомендуется сменить медицинское учреждение, в котором проводилось ЭКО. В случае, когда причиной неудачи является мужской фактор, требуется обратиться на консультацию к другому врач-андрологу.
Проблемы с эндометрием
Среди них его структура, рецептивная активность и способность к трансформации. Данные измерения позволяют вычислить «рецептивное окно» –промежуток времени наибольшей восприимчивости матки. В этот период увеличивается шанс успешного наступления беременности.
Спайки в области органов малого таза, рубцы, миоматозные узлы, полипы и другие новообразований могут мешать зародышу прикрепиться к эндометрию. Инфекционные патологии эндометрия – еще одна причина неудачного завершения протокола. Их опасность заключается в бессимптомном течении.
Поражения маточных труб
Патологические процессы в области фаллопиевых труб — причина попадания в матку токсических выделений. Они могут повлиять на эмбрион и помешать ему внедриться во внутренний слой матки. Для исключения данного фактора перед экстракорпоральным оплодотворением рекомендуется пройти лапароскопию. При диагностировании поражений в некоторых случаях показано удаление фаллопиевой трубы.
Несовместимость партнеров на иммунологическом уровне
В результате активируются процессы ее уничтожения. Подобная ситуация сводит к минимуму вероятность выживаемости зародыша. Современная репродуктология позволяется справиться с этой проблемой с помощью HLA-типирования. Диагностика позволяет выявить схожие антигены супругов. При их обнаружении паре назначается терапия, активирующая активную или пассивную иммунизацию.
Генетические аномалии
Основная проблема генетической аномалии заключается в том, что мужчина и женщина могут не подозревать, что являются носителями патологического гена. Клинические он не проявляется себя, однако, может предаться по наследству. Пройти диагностику, выявляющую наличие хромосомных отклонений, рекомендовано всем парам, вступающим в протокол ЭКО.
Процедура кариотипирования дает возможность выявить качественные и количественные изменения в хромосомном наборе супругов. Это необходимо для выявления вероятности передачи генетической патологии последующим поколениям. Если кариотипирование не было проведено, то вероятность подсадки генетически мутированного эмбриона увеличивается в несколько раз. После того, как врач получит готовые эмбрионы, их можно проверить с помощью предимплантационной генетической диагностики. Ее использование необходимо для выявления зародышей с наследственной патологией.
К другим факторам, препятствующим успешному экстракорпоральному оплодотворению, относятся:
Еще интересней:
- неправильно составленный план протокола экстракорпорального оплодотворения;
- врачебные ошибки.
Ошибки врачей
В таких случаях рекомендуется сменить лекарственные препараты и продолжительность протокола. Это приведет к успешному оплодотворению с развитием беременности. Другой врачебной ошибкой является подсаживание травмированных эмбрионов. Это происходит при слишком быстром введении зародыша в полость матки. Выходом из ситуации будет смена медицинского учреждения, где принимают более квалифицированные специалисты.
Как проходит созревание эмбрионов?

Для того, чтобы осуществить перенос эмбрионов, у женщины производят забор яйцеклеток, которые после оплодотворения помещают в пробирку для развития. Процесс извлечение яйцеклеток проводят под общей анестезией. Полученные зиготы выращивают в течение нескольких суток. Когда эмбрионы достигают состояния, при котором они могут беспрепятственно имплантироваться в матку, врачи принимают решение об их вживлении в организм. Эту дату определяют эмбриолог и репродуктолог.
Обычно для будущей беременности отбирают два эмбриона, женщинам после 40 допустим отбор трех эмбрионов. Если семейная пара планирует иметь еще детей в будущем, возможна криоконсервация (заморозка) оставшихся эмбрионов, которая позволяет сохранить их жизнеспособность в течение длительного времени. Врачи подтверждают, что успешное наступление беременности после ЭКО напрямую не зависит от того, были использованы обычные яйцеклетки или материал после замораживания.
Перед процедурой оплодотворения супружеская пара должна соблюдать определенные правила. Женщине следует избегать психоэмоциональных расстройств, отказаться от курения и принятия спиртных напитков, исключить острые и жареные блюда, а также физические нагрузки.
Определенных правил должен придерживаться и мужчина. За несколько дней до сдачи спермы следует тщательно следить за питанием, не принимать лекарственные препараты. Перед сдачей спермы в течение 3-4 дней желательно воздерживаться от половой близости. При наличии вирусных или инфекционных заболеваний процедуру сдачи спермы следует отложить.
Причины неудачных попыток ЭКО
К сожалению, не все попытки ЭКО приводят к такой желанной беременности, процент неудачных попыток очень высок и варьирует по разным данным.
Достаточно часто причины неудач ЭКО связаны с нежизнеспособностью эмбрионов, их сниженной способностью к делению.
Помимо этого есть другие причины, к которым относятся:
- Остановка развития эмбриона, после удачного оплодотворения.
- Патологические изменения эндометрия (хронические воспалительные заболевания эндометрия, полипы эндометрия, гиперплазия, онкопатология).
- Заболевания, связанные с маточными трубами.
- Инфекционно-воспалительные заболевания половой системы.
- Генетическая патология у будущих родителей, а также генетические аномалии эмбриона.
- Индивидуальная несовместимость супругов.
- Патология иммунной системы (антитела в организме женщины, которые препятствуют наступлению беременности).
- Эндокринная патология (гормональные сбои).
- Метаболические нарушения (ожирение).
- Вредные привычки (курение, алкоголь, наркотические вещества).
- Женщина не соблюдает предписания врача-репродуктолога и нарушает режим лечения.
- Недостатки диагностики сопутствующей патологии.
- Яйцеклетки, которые непригодны для оплодотворения.
- Сперматозоиды сниженного качества.
- Хроническая сопутствующая патология (печени, почек, ЖКТ, дыхательной системы, половых органов).
- Врачебные ошибки.
Не исключаются также и другие факторы, которые могли привести к гибели эмбриона. Очень важным аспектом в этом вопросе является состояние здоровья и физиологических резервов организма будущей матери, способности её организма к имплантации эмбриона и вынашиванию беременности. Чем ЭКО беременность отличается от обычной? Кроме метода попадания эмбриона в полость матки, собственно говоря, ничем.
Неудачи после ЭКО — это не приговор, и часто требуется несколько попыток для наступления желанной беременности. Для многих пар сохранить надежду и эмоциональную стабильность после неудачной попытки экстракорпорального оплодотворения является достаточно тяжелой задачей, поэтому эту проблему тоже стоит рассмотреть.





















































































































